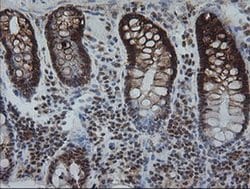
Invitrogen KIF25 Monoclonal Antibody (OTI2F4) 100 &mu;L; Unconjugated:Antibodies,

missing translation for 'onlineSavingsMsg'
Learn More
Learn More
Invitrogen™ KIF25 Monoclonal Antibody (OTI2F4)


Mouse Monoclonal Antibody
Brand: Invitrogen™ MA526132
This item is not returnable.
View return policy
Description
KIF25 Monoclonal Antibody for Western Blot, ICC/IF, IHC (P)
The protein encoded by this gene is a member of the kinesin-like protein family. Protein family members are microtubule-dependent molecular motors that transport organelles within cells and move chromosomes during cell division. However, the particular function of this gene product has not yet been determined. Two alternatively spliced transcript variants which encode products have been described. Other splice variants have been found that lack exon 2 and the initiation codon for translation.
Specifications
| KIF25 | |
| Monoclonal | |
| 1 mg/mL | |
| PBS with 1% BSA, 50% glycerol and 0.02% sodium azide; pH 7.3 | |
| Q9UIL4 | |
| KIF25 | |
| Full length human recombinant protein of KIF25 produced in HEK293T cell. | |
| 100 μL | |
| Primary | |
| Human | |
| Antibody | |
| IgG1 |
| Immunohistochemistry (Paraffin), Western Blot, Immunocytochemistry | |
| OTI2F4 | |
| Unconjugated | |
| KIF25 | |
| KIF25; kinesin family member 25; kinesin-like 3; kinesin-like protein 3; Kinesin-like protein KIF25; KNSL3 | |
| Mouse | |
| Affinity Chromatography | |
| RUO | |
| 3834 | |
| -20°C, Avoid Freeze/Thaw Cycles | |
| Liquid |
Product Content Correction
Your input is important to us. Please complete this form to provide feedback related to the content on this product.
Product Title
Spot an opportunity for improvement?Share a Content Correction